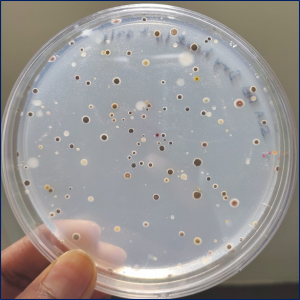
Bionexus

Pune, Maharashtra Dec 20, 2021 (Issuewire.com) - Bioprime becomes the first deep tech Life science start-up to raise investment from Omnivore’s OmniX Bio
Bioprime Agrisolutions Pvt Ltd incubated at Venture Center, NCL Innovation Park and founded by 3 scientists from the Savitribai Phule University of Pune becomes the first Ag biotech start-up to receive investment from the country’s biggest Agri focused VC fund, Omnivore. Omnivore launched OmniX Bio to support agrifood and Life sciences start-ups in the country.
The recent rise and focus on the Agri sector with record-breaking deal sizes have indeed been encouraging. However, this also brings to the focus the complete absence of deep tech-based life sciences start-ups, and fundings in India. This is even more surprising given the fact that the US, Europe, Singapore have made billon dollar investments in Agri life sciences.
Climate change affects 70% of agriculture causing a 21% loss in productivity globally. A recent study shows that climate change in the last 30 years has wiped off 6 years of progress made. Bioprime aims to change that by making crops climate-resilient using targeted physiology modulating biomolecules.
At Bioprime we are focusing on discovering fundamental aspects of plant communication, identifying new biomolecules and new modes of modulating plant responses. SNIPR (Smart Nanomolecules Induced Physiological Response- a high throughput multi-disciplinary screening platform) and BIONEXUS (country's largest trait modifying, plant-associated microbe collection) enable Bioprime to develop new biologicals and radically improve existing products at a fraction of cost and time. These products are crop agnostic, rapid-acting, certified organic, residue-free, and can be used by farmers on as is where is basis irrespective of farmland size. The 1st gen of products is at an early commercialization stage and the company is evaluating several pan India distribution partnerships for its SNIPR Biologicals portfolio. With several co-development partnerships with MNCs under their belt, Bioprime is well on its way to establishing itself as a global player in Ag biotech.
Bioprime has won several awards and recognition for their first in class biologicals like FICCI Startup awards, Best Agri Inputs company, Agri Awards, Social Alpha agritech challenge, Tie-BIrac Winner and are a finalist in the National Startup Awards. They are also one of the top 5 companies in the ongoing Cisco Agri Challenge.
Speaking about the funding Dr. Renuka Karandikar, CEO said “With this funding, we will strengthen and advance our capabilities in screening, gain regulatory approvals of the current portfolio and expand operations pan India. With Omnivore joining us in this journey we are confident of building Bioprime to be a global player in Ag biotech and achieve our goal of a world where good yield is not a gamble but an assurance.”
Mark Kahn, the Managing Partner of Omnivore, said, “We are excited to launch OmniX Bio to help reboot the agrifood life sciences ecosystem in India. Technological advances in this space can effectively solve some of the toughest challenges in Indian agriculture. In BioPrime, we have a great example of an innovation designed to improve both human and planetary health. We hope to see more entrepreneurs like the BioPrime team step up to the challenge and help change the course of Indian agriculture for the better.”
Media Contact
Bioprime Agrisolutions info@bioprimeagri.com Dr Renuka Karandikar Bioprime Agrisolutions Pvt Ltd https://www.bioprimeagri.com/